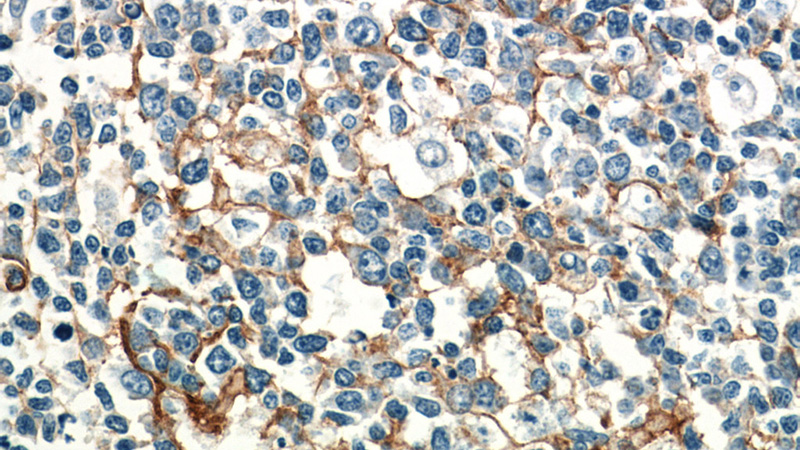
Immunohistochemistry of paraffin-embedded human tonsillitis tissue slide using Catalog No:111587(ICAM-1 Antibody) at dilution of 1:50 (under 40x lens)
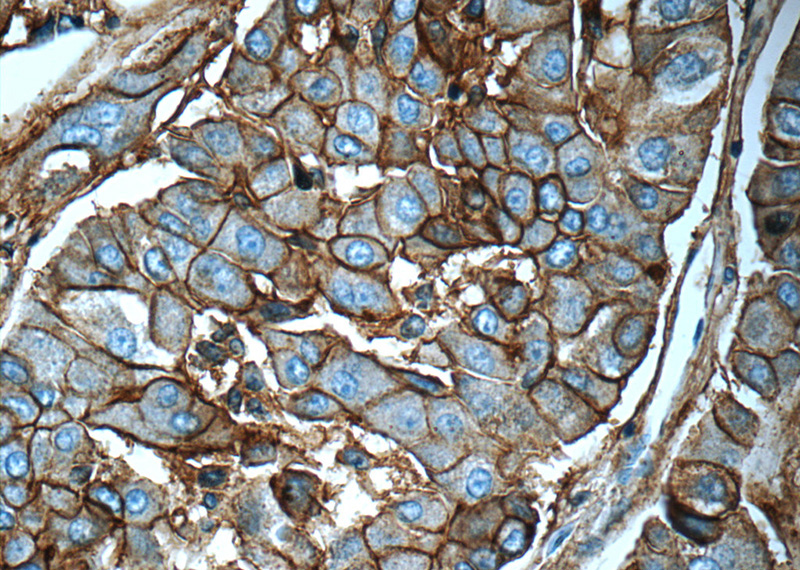
Immunohistochemistry of paraffin-embedded human liver cancer tissue slide using Catalog No:111587(ICAM-1 Antibody) at dilution of 1:50 (under 40x lens)

-
Product Name
ICAM-1 antibody
- Documents
-
Description
ICAM-1 Rabbit Polyclonal antibody. Positive WB detected in L02 cells, mouse liver tissue, Raji cells. Positive IP detected in Raji cells. Positive IHC detected in human lung cancer tissue, human liver cancer tissue, human tonsillitis tissue. Positive FC detected in Raji cells. Observed molecular weight by Western-blot: 85-95 kDa
-
Tested applications
ELISA, WB, IHC, IP, FC
-
Species reactivity
Human, Mouse; other species not tested.
-
Alternative names
BB2 antibody; CD54 antibody; ICAM 1 antibody; ICAM1 antibody; P3.58 antibody
-
Isotype
Rabbit IgG
-
Preparation
This antibody was obtained by immunization of ICAM-1 recombinant protein (Accession Number: NM_000201). Purification method: Antigen affinity purified.
-
Clonality
Polyclonal
-
Formulation
PBS with 0.1% sodium azide and 50% glycerol pH 7.3.
-
Storage instructions
Store at -20℃. DO NOT ALIQUOT
-
Applications
Recommended Dilution:
WB: 1:200-1:2000
IP: 1:500-1:5000
IHC: 1:20-1:200
-
Validations

L02 cells were subjected to SDS PAGE followed by western blot with Catalog No:111587(ICAM-1 antibody) at dilution of 1:800

Immunohistochemical of paraffin-embedded human lung cancer using Catalog No:111587(ICAM-1 antibody) at dilution of 1:50 (under 25x lens)

IP Result of anti-ICAM-1 (IP:Catalog No:111587, 4ug; Detection:Catalog No:111587 1:1000) with Raji cells lysate 1320ug.
Immunohistochemistry of paraffin-embedded human tonsillitis tissue slide using Catalog No:111587(ICAM-1 Antibody) at dilution of 1:50 (under 40x lens)
Immunohistochemistry of paraffin-embedded human liver cancer tissue slide using Catalog No:111587(ICAM-1 Antibody) at dilution of 1:50 (under 40x lens)

1X10^6 Raji cells were stained with 0.2ug ICAM-1 antibody (Catalog No:111587, red) and control antibody (blue). Fixed with 90% MeOH blocked with 3% BSA (30 min). Alexa Fluor 488-congugated AffiniPure Goat Anti-Rabbit IgG(H+L) with dilution 1:1000.
-
Background
ICAM-1 (CD54) is a 90-kDa transmembrane glycoprotein of the immunoglobulin superfamily and is critical for the firm attachment and transmigration of leukocytes out of blood vessels and into tissues (PMID: 19307690). ICAM-1 is expressed by several cell types, typically on endothelial cells and cells of the immune system, and its expression can be up-regulated by various stimuli, including TNF-α, INF-γ, IL-1 and thrombin (PMID: 3086451; 9694714; 15979056). It is a ligand for LFA-1 and Mac-1, serves as a receptor for rhinovirus, and is one of several receptors used by Plasmodium falciparum (PMID: 2566624; 2538244; 2475784). Read more about this antibody on the blog:http://blog.ptglab.com/index.php/tracking-cancer-vacularization-and-progression-with-proteintechs-icam-1-antibody/
-
References
- Du Y, Kowluru A, Kern TS. PP2A contributes to endothelial death in high glucose: inhibition by benfotiamine. American journal of physiology. Regulatory, integrative and comparative physiology. 299(6):R1610-7. 2010.
- Ohkubo Y, Iwakawa M, Seino K. Combining carbon ion radiotherapy and local injection of α-galactosylceramide-pulsed dendritic cells inhibits lung metastases in an in vivo murine model. International journal of radiation oncology, biology, physics. 78(5):1524-31. 2010.
- Rinella ME, Siddiqui MS, Gardikiotes K, Gottstein J, Elias M, Green RM. Dysregulation of the unfolded protein response in db/db mice with diet-induced steatohepatitis. Hepatology (Baltimore, Md.). 54(5):1600-9. 2011.
- Talahalli R, Zarini S, Tang J. Leukocytes regulate retinal capillary degeneration in the diabetic mouse via generation of leukotrienes. Journal of leukocyte biology. 93(1):135-43. 2013.
- Tang J, Allen Lee C, Du Y. MyD88-dependent pathways in leukocytes affect the retina in diabetes. PloS one. 8(7):e68871. 2013.
- Hu X, Liu Y, Qin C. Up-regulated isocitrate dehydrogenase 1 suppresses proliferation, migration and invasion in osteosarcoma: in vitro and in vivo. Cancer letters. 346(1):114-21. 2014.
- Jin Y, Liu K, Peng J. Rhizoma Dioscoreae Nipponicae polysaccharides protect HUVECs from H2O2-induced injury by regulating PPARγ factor and the NADPH oxidase/ROS-NF-κB signal pathway. Toxicology letters. 232(1):149-158. 2014.
- Mou W, Xu Y, Ye Y. Expression of Sox2 in breast cancer cells promotes the recruitment of M2 macrophages to tumor microenvironment. Cancer letters. 358(2):115-23. 2015.
Related Products / Services
Please note: All products are "FOR RESEARCH USE ONLY AND ARE NOT INTENDED FOR DIAGNOSTIC OR THERAPEUTIC USE"
